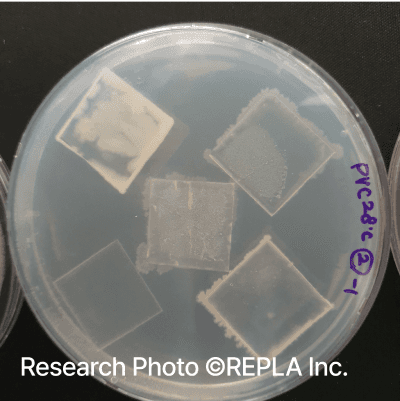

Our goal is infinite plastic recycling using bacteria.

Repla’s Bacteria
Degrading PE While Retaining PP
Tackling a Recycling Challenge: Conventional recycling struggles to separate polypropylene (PP) and polyethylene (PE) due to their similar physical properties. Repla overcomes this limitation with bacteria capable of selective degradation, promoting purity enhancement technology.
High-Quality Recycled PP: Repla’s bacterial treatment delivers recycled PP with quality comparable to new plastics, increasing its market value and expanding its application. This ultimately enhances the profitability of the recycling industry.

Degrade Plastics, Upgrade Purity
How Repla’s Bacteria Degrades PE While Preserving PP
Step 1
Bacterial Action Weakens Plastic Bonds
Step 2
Fatty Acid Plastics Consumed by Bacteria
Step 3
Complete Degradation of Target Plastics
Technical data
Bacteria-Enhanced Recycled PP Properties:
Tensile strength improved by 67% and flexural strength by 29%, making it suitable for use in high-quality applications such as home appliances and automotive components.
Tensile strength
Repla’s bacterial treatment enhances recycled PP properties to nearly 67% of the quality of new PP.
Flexural strength
Repla’s bacterial treatment enhances recycled PP properties to nearly 29% of the quality of new PP.

Publications
Biodegradation of Polystyrene by Pseudomonas sp. Isolated from the Gut of Superworms (Larvae of Zophobas atratus)
Kim et al. (2020)
Rapid biodegradation of polyphenylene sulfide plastic beads by Pseudomonas sp.
Li et al. (2020)
Evaluation of the Biodegradation Efficiency of Four Various Types of Plastics by Pseudomonas aeruginosa Isolated from the Gut Extract of Superworms
Lee et al. (2020)
Isolation of a polyethylene-degrading bacterium, Acinetobacter guillouiae, using a novel screening method based on a redox indicator
Kim et al. (2023)
Kim et al. (2023)
Kim et al. (2024)
Patents
Novel Bacteria with Plastic-Degrading Activity and Its Applications
Novel Bacteria with Plastic-Degrading Activity and Its Applications
Microorganism isolated from tenebrio molitor larva and having plastic degrading activity, and method for degrading plastic using same
Method for Enhancing the Quality of Recycled Plastics Using Bacteria
